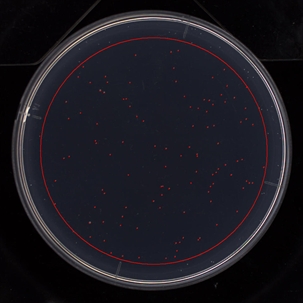

自動菌落計數儀
AUTOMATIC COLONY COUNTER

日本進口,世界最新的菌落計數儀
the most advanced automatic colony counter
PSF-1100/2200/5200/7200

一、自動菌落計數儀,解決菌落計數的各種問題
① 每天有大量樣品。人工計數耗時太長,耽誤了其他工作。計數操作導致頸部和肩部僵硬。
原始圖像
| ![]() | 結果圖像
|
解決方案
對于菌落數超過300個的培養皿,手工計測需要5分鐘,使用自動菌落計數儀高速圖像處理操作便捷,一個樣本約3秒鐘可以完成,只需一個技術人員即可完成更多的樣本計測。
② 人工目測難以精確的計測,例如計測直徑大于0.5mm的大腸菌時。根據當天的身體狀況,可能會漏計一些小菌落。
原始圖像
| ![]() | 結果圖像
|
解決方案
可以通過設定菌落的大小來測菌落數,進行穩定的計測。
③培養基表面上的大菌落下可能存在小的菌落。
原始圖像
| ![]() | 結果圖像
|
解決方案
可以自動刪除大型菌落。并可以從能夠精確計數的部分算出培養皿全域的CFU。
④PSF系列使用高分辨率數碼彩色相機。 只需單擊圖像上的目標菌落,即可輕松設置分色計測條件。
原始圖像
| ![]() | 結果圖像
|
解決方案
在一次計測中,可以分別計算多達4種類型的菌落。例如,“按4種顏色分離”、“按2種顏色和2種大小分離”、“按顏色或亮度分離”等都是可能的。
⑤菌落的形狀各不相同,但能自動計測嗎?
原始圖像
| ![]() | 結果圖像
|
解決方案
可以通過顏色或亮度分離菌落,而且計測結果不會受菌落形狀的影響。
⑥ 是否可以計測培養基中有殘留物或沉積物的樣品?
原始圖像
| ![]() | 結果圖像
|
解決方案
只要菌落和殘留物或沉積物之間的大小、亮度或顏色存在差異,則可以計測。
⑦菌落不清楚而且很小。能計測它們嗎?
原始圖像
| ![]() | 結果圖像
|
解決方案
通過設置計測條件,可以指定培養基中明亮的部分被識別為菌落。如果培養基制備(厚度等)恒定,則可獲得穩定的結果。
⑧菌落很大,而且相互連接。能分離計測嗎?
原始圖像
| ![]() | 結果圖像
|
解決方案
可以自動分離和計測連接或重疊的菌落。
技術參數
| 型式 | PSF-7200 | PSF-5200 | PSF-2200 | PSF-1100 |
|---|---|---|---|---|
| 本體尺寸 | 約W280×D351×H630 mm | |||
| 重量 | 本體 約19 kg | |||
| 電源 | AC 1φ100-240V 50/60Hz | |||
| 系統構成 | 本體(數據處理用電腦,顯示器另外銷售) | |||
| 動作環境 | 溫度10℃-35℃, 濕度20%-80% | |||
| 相機種類 | USB3.0彩色 CMOS | USB2.0彩色 CMOS | ||
| 像素數 | 2000萬 | 1200萬 | 600萬 | 300萬 |
| 計算分辨率 | 28 μm | 34 μm | 50 μm | 67 μm |
| 實測分辨率 | 35 μm | 53 μm | 71 μm | 99 μm |
| 計測對象 | 培養皿,濾膜,膠片介質上的菌落。溶菌斑(噬菌斑)或抑菌圈。 | |||
| 培養皿 | Φ100mm以下的圓形培養皿(標準搭配) | |||
| 微孔板 | 6,12,24孔的微孔板(需要配選軟件) | |||
| 最大計測領域尺寸 | 約 100×134 mm | |||
| 計測時間 | 約1-5秒/1培養皿 | |||
| 最多計數菌落數 | 20,000個菌落數(可以更改設置) | |||
| 外光屏蔽 | 遮光滑動門 | 防塵罩 遮光滑動門為可選配件 | ||
| 上部照明 | 高度可調型(反射光) | 固定型 | ||
| 下部照明 | 明場,暗場 | |||
| 照明開/關 | 由軟件控制 | 手動 | ||
| 明暗場切換 | 由軟件控制 | 手動 | ||
* 上部照明的高度位置可以改變.
由此可以清楚地拍攝菌落的輪廓。
資訊中心
- 公司成為日本ICOMES公司電動移液器pipetty產品中國區總代理 2020-10-09
- 廣州市程淇生物參加第25屆藥品質量安全大會暨展覽會精彩回顧 2026-05-29
- 32通道移液工作站在禽流感檢測血凝抑制實驗(HI實驗)中的應用 2026-05-07
- 實驗室福音|一款可放入生物安全柜或潔凈臺的小型自動移液工作站 2026-04-30
- RAYPA公司攜頂尖的培養基自動制備儀器亮相2026 analytica 2026-04-08
- 廣州程淇生物公司在第二屆海南食品安全檢測技術研討會的精彩回顧 2025-11-12
- Pipetty電動移液器在基孔肯雅病毒核酸檢測(實時熒光-PCR)中的應用 2025-07-18
- ICOMES公司參加第 30 屆 Machine Element Technology Expo 2025-07-09